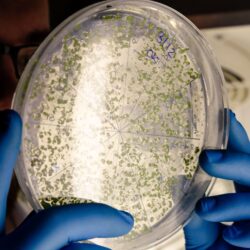

Nous vous conseillons de prendre 2 gélules par jour, pendant 2 mois (pour adultes et adolescents). En cas de gênes importantes, augmentez à 4 gélules par jour pendant une semaine, puis réduisez à 2 gélules par jour pendant 2 mois.
Convient également aux femmes enceintes seulement avec l’accord du médecin traitant, gynécologue ou de la sage-femme.
Quand : Le matin à jeun, ou 30 mins avant un repas.
Le pilulier : 60 gélules pour 30 jours (1 mois).
Conservation & Précautions d’emploi :
À conserver dans un endroit sec, frais et à l'abri de la lumière. Tenir hors de portée des jeunes enfants.
Complément alimentaire à base de substances à but nutritionnel ou physiologique. À consommer avec une alimentation variée et équilibrée associée à un mode de vie sain. Bien respecter les doses journalières indiquées.